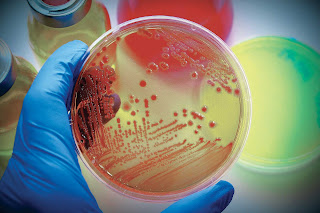

Renewable energy is an increasing need in our society. Microbial fuel cell MFC technology is a bioreactor that converts organic waste material into electrical energy through catalytic reactions of microorganisms. This environmentally friendly process produces electricity without the combustion of fossil fuel. The objective of this study was to isolate Exoelectrogenic microorganisms with a potential to generate electricity and simultaneously treat waste water. The polluted water used in this study was obtained from Ulhas river Dist. Thane, Maharashtra and analysed for pH, salinity, hardness TDS, TSS, TS, COD and BOD. Exoelectrogenic bacteria were isolated from the polluted water sample and screened their ability to generate electricity by constructing cost effective MFC. The potential exoelectrogenic bacteria were then identified as E.coli, Pseudomonas spp and S. aureus spp. Thus, the selected exoelectrogenic bacteria can be used for waste water treatment alongwith generation of electricity thereby reducing the environmental pollution.
by Asmita Genge | Ranjana Khade "Isolation and Screening of Exoelectrogenic Bacteria from Waste Water"
Published in International Journal of Trend in Scientific Research and Development (ijtsrd), ISSN: 2456-6470, Volume-3 | Issue-3 , April 2019,
URL: https://www.ijtsrd.com/papers/ijtsrd23352.pdf
Paper URL: https://www.ijtsrd.com/biological-science/microbiology/23352/isolation-and-screening-of-exoelectrogenic-bacteria-from-waste-water/asmita-genge
call for paper economics, economics journal


No comments:
Post a Comment